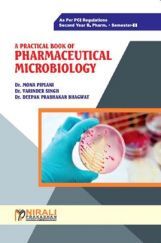

- Higher Education
Loading Higher Education...
- Professional Courses
Loading Professional Courses...
- Competitive Exams
Loading Competitive Exams...
- School
Loading School...
- Study Packages
Loading Study Packages...
- Free eBooks
Loading Free eBooks...
- Mock Test Series
Loading Mock Test Series...
- Videos
Loading Videos...
- Blog